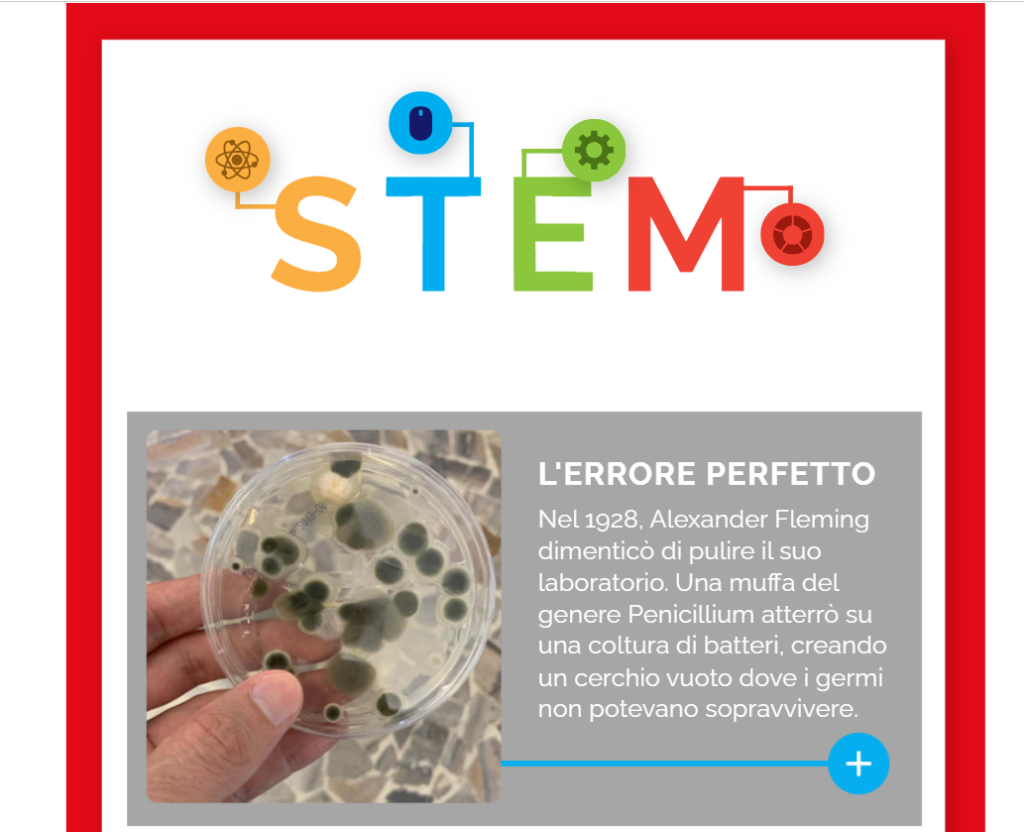

Sfoglia in anteprima le pagine del libro , accedendo alla versione digitale e provando i contenuti digitali dimostrativi che abbiamo realizzato.
Ti proponiamo inoltre alcuni esempi dei contenuti digitali che arricchiscono e integrano la proposta didattica dei volumi: clicca sulle immagini e sui bottoni per accedere ai materiali per la classe.

Assistente per lo studio AI
Un assistente virtuale che sfrutta l’Intelligenza Artificiale Generativa per supportare lo studio e l’apprendimento.

Tavole interattive
Contenuti da esplorare su LIM o tablet, per un apprendimento attivo e coinvolgente
Esercizi e verifiche interattive
Lezioni e percorsi interattivi relativi a temi specifici, caratterizzati da esercizi formativi, finalizzati al consolidamento delle conoscenze e allo sviluppo delle abilità.

Studio il corpo umano in 3D
“Il corpo umano in 3D” consente di esplorare l’anatomia in modo visivo e coinvolgente.
Grazie ai suoi modelli tridimensionali esplorabili, questo strumento facilita la comprensione di apparati e sistemi complessi catturando l’attenzione della classe.
È la soluzione ideale per arricchire le vostre lezioni di scienze, perfetta per essere proiettata sulla LIM o per l’assegnazione di approfondimenti individuali.

Laboratori operativi
Una selezione realizzata da musei e enti di ricerca per proporre attività operative alla classe

Fonti e approfondimenti
Repertorio di testi integrativi e iconografia, per esplorare le fonti e allargare lo sguardo alla realtà in cui viviamo.
